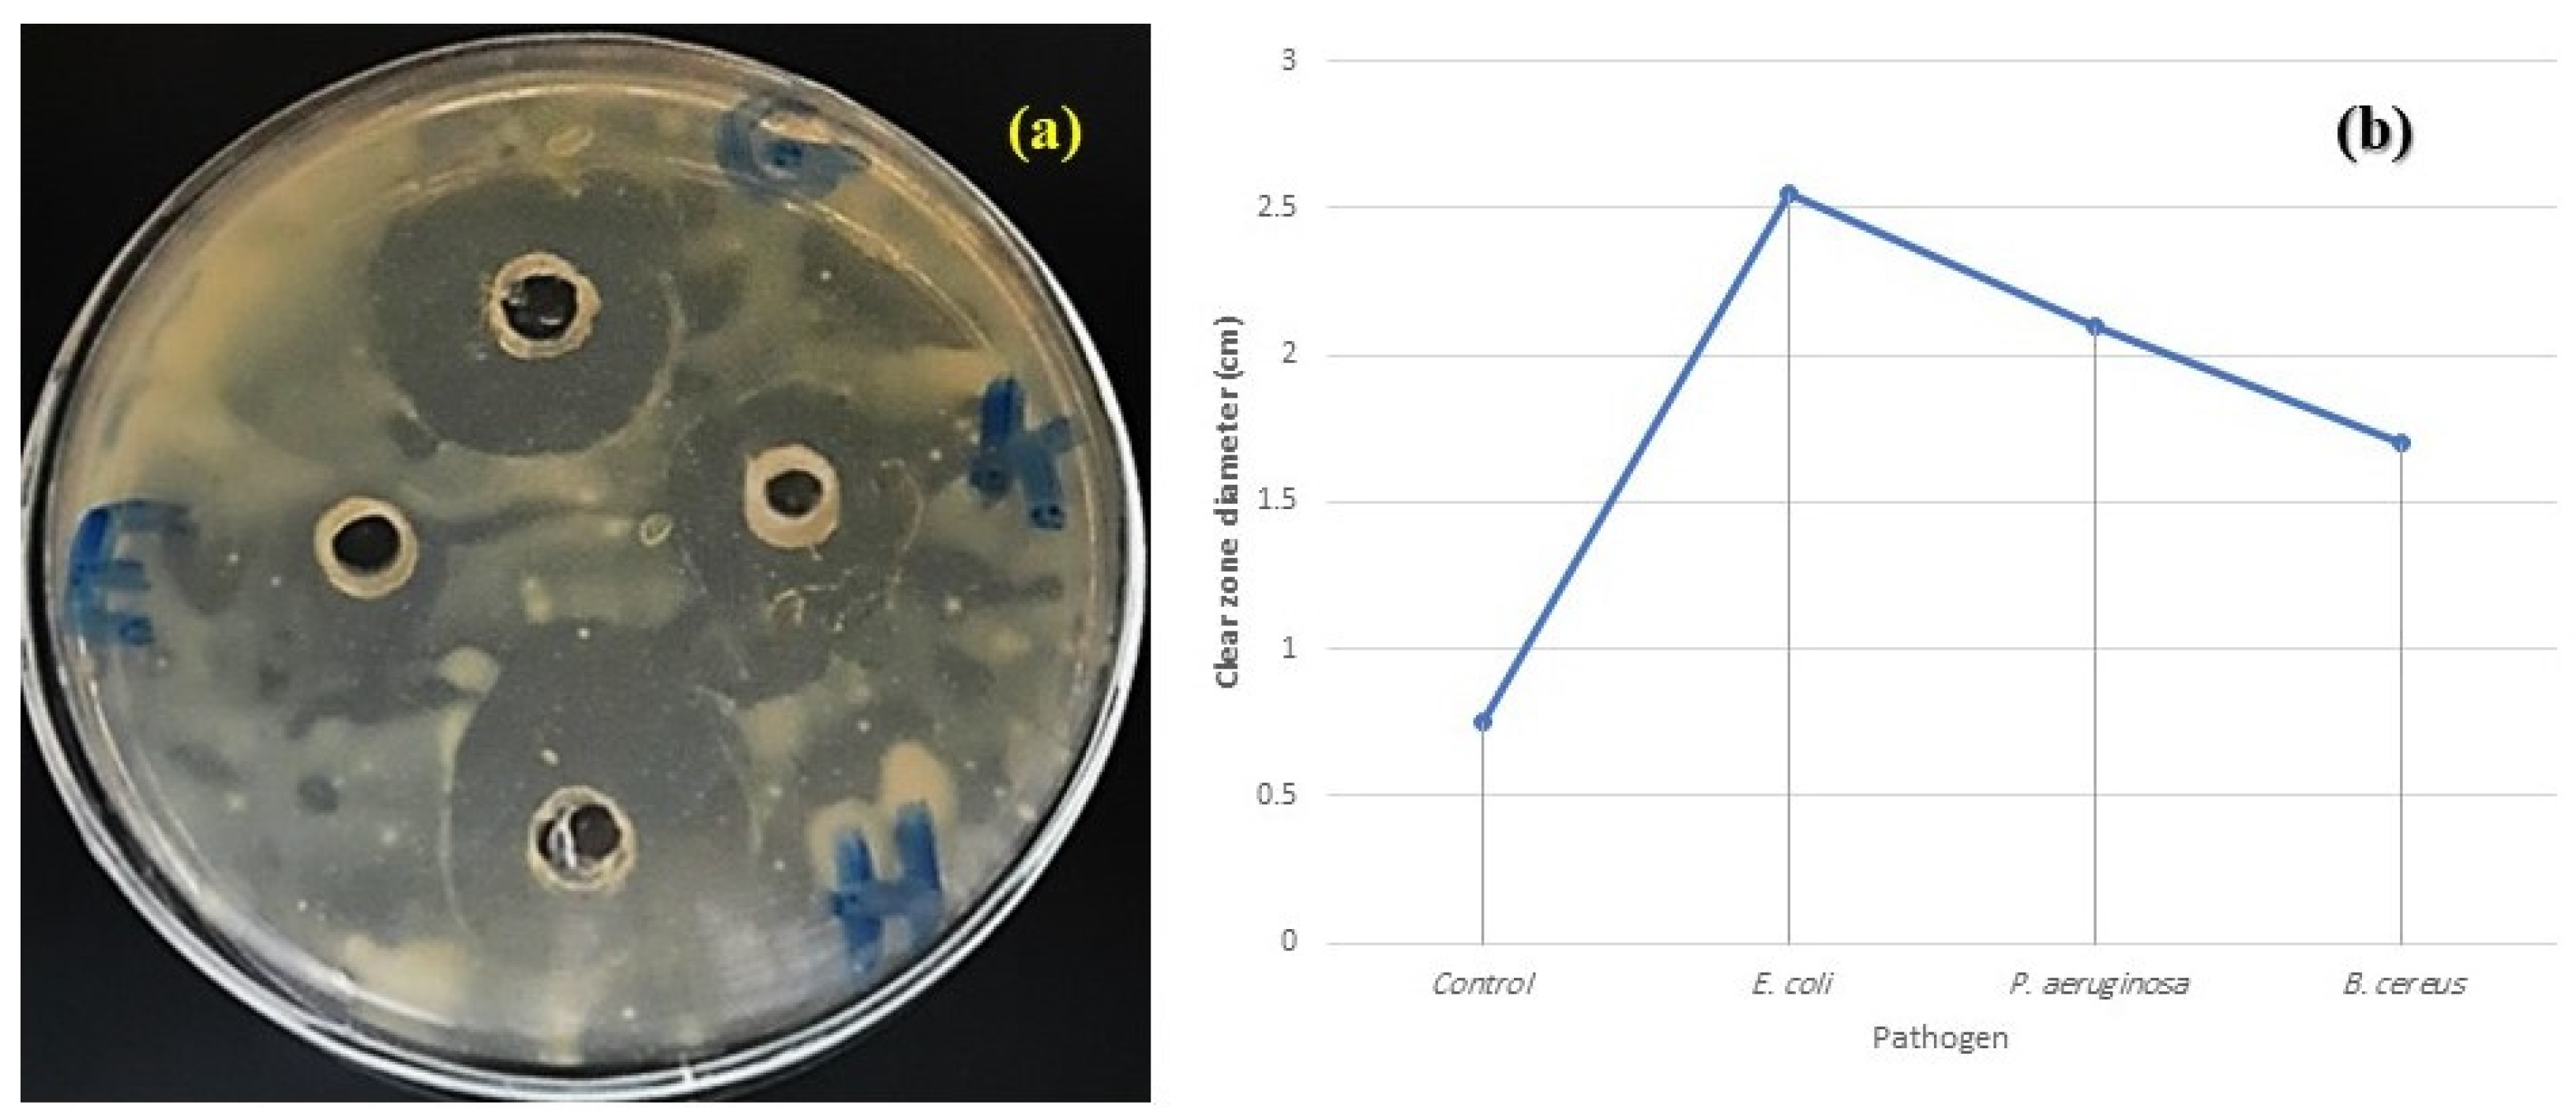

Molecular Identification of Zantedeschia Culture with Determination of Its Morphometric and Metabolic Activities for Mediterranean Acclimatization
Abstract
1. Introduction
2. Results
2.1. Plan Identification
2.1.1. Floral Identification
2.1.2. The Digital Identification of Zantedeschia
2.1.3. The Molecular Identification of Zantedeschia
2.2. Morphological Description
2.3. Physiological Parameters
2.3.1. Measured Metabolites
2.3.2. GC–MS for Oil Content
2.3.3. LC–MS for Ethanol Extract
2.4. Anatomical Studies
2.5. Cytological Studies
2.6. Antimicrobial Activity
3. Discussion
4. Materials and Methods
4.1. Plant Material
4.2. In Vitro Culture Conditions and Multiplication
4.3. Plant Identification
4.3.1. Floral Identification
4.3.2. Digital Identification
4.3.3. Molecular Identification
DNA Extraction
18S rRNA PCR Amplification
4.4. Morphological Description
4.5. Physiological Parameters
4.5.1. Chlorophyll Index
4.5.2. Pigmentation
4.5.3. Total Proteins
4.5.4. Total Phenolic Compounds
4.5.5. Total Flavonoids
4.5.6. Total Oil extract and GC-MS Analysis for Zantedeschia Essential Oils
4.5.7. Preparation of Zantedeschia Methanol Extract and LC–MS
4.6. Anatomical Description
4.7. Cytological Studies
4.8. Antimicrobial Activity of Zantedeschia Extract
4.9. Statistical Analysis
5. Conclusions
Author Contributions
Funding
Informed Consent Statement
Data Availability Statement
Acknowledgments
Conflicts of Interest
References
- Funnell, K.A. The genus Zantedeschia. In Botanical Classification and Morphology; New Zealand Calla Council: Auckland, New Zealand, 2006. [Google Scholar]
- Slaughter, R.J.; Beasley, D.M.; Lambie, B.S.; Wilkins, G.T.; Schep, L.J. Poisonous plants in New Zealand: A review of those that are most commonly enquired about to the National Poisons Centre. N. Z. Med. J. 2012, 125, 87–118. [Google Scholar] [PubMed]
- Burrows; George, E.; Tyrl, R.J. Zantedeschia . In Toxic Plants of North America, 2nd ed.; John Wiley & Sons: Hoboken, NJ, USA, 2012; pp. 141–142. [Google Scholar]
- Cohen, D. Micropropagation of Zantedeschia hybrids. Comb. Proc. Int. Plant Prop. Soc. 1981, 31, 312–316. [Google Scholar]
- Clemens, J.; Welsh, T.E. An overview of the New Zealand calla industry, research direction and year round tuber production. Acta Hortic. 1993, 337, 161–166. [Google Scholar] [CrossRef]
- Fang, W.L.; Xiong, L.; Qu, Y.H.; Qu, S.P. Tissue culture of colored common calla lily. J. South West Agric. Univ. 1999, 21, 423–426. [Google Scholar]
- Ruiz, S.G.; Rosa, M.E.; Flores, O.C.E. Zantedeschia aethiopica, propagation by tissue culture. J. Agric. Univ. Puerto Rico 1996, 80, 193–194. [Google Scholar]
- Kürschner, W.; Stulen, I.; Wagner, F.; Kuiper, P. Comparison of palaeobotanical observations with experimental data on the leaf anatomy of durmast oak (Quercus petraea) (Fagaceae) in response to environmental changes. Ann. Bot. 1998, 81, 657–664. [Google Scholar] [CrossRef]
- Bayer, R.J.; Hufford, L.; Soltis, D.E. Phylogenetic relationships in Sarraceniaceae based on rbcLand ITS sequences. Syst. Bot. 1996, 21, 121–134. [Google Scholar] [CrossRef]
- Hedderson, T.A.; Chapman, R.L.; Cox, C.J. The origins and diversification of land plants: New evidence from molecules. In Bryology for the Twenty-First Century; Ashton, N.W., Bates, J.W., Duckett, J.G., Eds.; Maney: Leeds, UK, 1998; pp. 65–77. [Google Scholar]
- Shinwari, Z.K.; Qaisar, M. Efforts on conservation and sustainable use of medicinal plants of Pakistan. Pak. J. Bot. 2011, 43, 5–10. [Google Scholar]
- Banaras, S.; Aman, S.; Zafar, M.; Khan, M.; Abbas, S.; Shinwari, Z.K.; Shakeel, S.N. Molecular Identification and Comparative Analysis of Novel 18s Ribosomal RNA Genomic Sequences of a Wide Range of Medicinal Plants. Pak. J. Bot. 2012, 44, 2021–2026. [Google Scholar]
- Ullah, F.; Gao, Y.; Sari, I.; Jiao, R.-F.; Saqib, S.; Gao, X.-F. Macro-Morphological and Ecological Variation in Rosa sericea Complex. Agronomy 2022, 12, 1078. [Google Scholar] [CrossRef]
- Sarjani, T.M.; Mawardi, M.; Pandia, E.S.; Wulandari, D. Identifikasi Morfologi dan Anatomi Tipe Stomata Family Piperaceae di Kota Langsa. J. IPA Pembelajaran IPA 2017, 1, 182–191. [Google Scholar] [CrossRef]
- Kulpa, D. Micropropagation of calla lily (Zantedeschia rehmannii). Folia Hortic. 2016, 28, 181–186. [Google Scholar] [CrossRef][Green Version]
- Sanchez, T.R.; Laffitte, C.O.; Gradaille, D.M.; Borrero, N.L.; Avila, B.M. In vitro plant propagation on Anthurium andreanum Lind. var. Sonate. Biotecnol. Veg. 2000, 1, 33–38. [Google Scholar]
- Chang, H.S.; Chakrabarty, D.; Hahn, E.J.; Paek, K.Y. Micropropagation of Calla Lily (Zantedeschia albomaculata) Via In Vitro Shoot Tip Proliferation. In Vitr. Cell. Dev. Biol.-Plant 2003, 39, 129–134. [Google Scholar] [CrossRef]
- Tawfik, E.; Fathy, M. Chemical Mutagens Affecting in vitro Behavior of Gardenia jasminoides. Plant Tissue Cult. Biotechnol. 2020, 30, 209–218. [Google Scholar] [CrossRef]
- Yao, J.L.; Cohen, D. Production of triploid Zantedeschia hybrids using embryo rescue. N. Z. J. Crop Hortic. Sci. 1996, 24, 297–301. [Google Scholar] [CrossRef]
- Wang, S.; Li, X.; Yang, L.; Wu, H.; Zheng, S.; Zhang, X.; Zhang, L. Microspore culture of Zantedeschia aethiopica: The role of monosaccharides in sporophytic development. Afr. J. Biotechnol. 2011, 10, 10287–10292. [Google Scholar] [CrossRef]
- Ghimire, B.K.; Yu, C.Y.; Kim, H.J.; Chung, I.M. Karyotype and nucleic acid content in Zantedeschia aethiopica Spr. and Zantedeschia elliottiana Engl. Afr. J. Biotechnol. 2012, 11, 11604–11609. [Google Scholar]
- Stuessy, T.F. Plant Taxonomy: The Systematic Evaluation of Comparative Data; Columbia University Press: New York, NY, USA, 2009. [Google Scholar]
- Judd, W.S. Taxonomic Evidence: Structure and Biochemical Character. In Plant Systematic: A Phylogenetic Approach; Sinaeur Ass. Inc.: Sunderland, MA, USA, 2002. [Google Scholar]
- Sawidis, T.; Kalyba, S.; Delivopoulos, S. The Root-Tuber Anatomy of Asphodelus aestivus. Flora 2005, 200, 332–338. [Google Scholar] [CrossRef]
- Evans, J.R.; Loretto, F. Acquisition and diffusion of CO2 in higher plant leaves. In Photosynthesis: Physiology and Metabolism; Leegood, R.C., Sharkey, T.D., von Caemmerer, S., Eds.; Kluwer Academic Publishers: Amsterdam, The Netherlands, 2000; pp. 321–351. [Google Scholar]
- Sims, D.A.; Pearcy, R.W. Response of leaf anatomy and photosynthetic capacity in Alocasia macrorrhiza (Araceae) to a transfer from low to high light. Am. J. Bot. 1992, 79, 449–455. [Google Scholar] [CrossRef]
- Burt, S. Essential oils: Their antibacterial properties and potential application in foods: A review. Int. J. Food Microbiol. 2004, 94, 223–253. [Google Scholar] [CrossRef] [PubMed]
- Gill, A.O.; Holley, R.A. Disruption of Escherichia coli, Listeria monocytogenes and Lactobacillus sakei cellular membranes by plant oil aromatics. Int. J. Food Microbiol. 2006, 108, 1–9. [Google Scholar] [CrossRef] [PubMed]
- Tiwari, B.K.; Valdramidi, V.P.; O’Donnell, C.P.; Muthukumarappan, K.; Bourke, P.; Cullen, P.J. Application of natural antimicrobials for food preservation. J. Agric. Food Chem. 2009, 57, 5987–6000. [Google Scholar] [CrossRef] [PubMed]
- Berahou, A.; Auhmani, A.; Fdil, N.; Benharref, A.; Jana, M.; Gadhi, C.A. Antibacterial activity of Quercus ilex bark’s extracts. J. Ethnopharmacol. 2007, 112, 426–429. [Google Scholar] [CrossRef]
- Saqib, S.; Nazeer, A.; Ali, M.; Zaman, W.; Younas, M.; Shahzad, A.; Nisar, M. Catalytic potential of endophytes facilitates synthesis of biometallic zinc oxide nanoparticles for agricultural application. Biometals 2022, 33, 1–19. [Google Scholar] [CrossRef]
- Liaquat, F.; Qunlu, L.; Arif, S.; Haroon, U.; Saqib, S.; Zaman, W.; Jianxin, S.; Shengquan, C.; Li, L.X.; Akbar, M.; et al. Isolation and characterization of pathogen causing brown rot in lemon and its control by using ecofriendly botanicals. Physiol. Mol. Plant Pathol. 2021, 114, 101639. [Google Scholar] [CrossRef]
- Mostafa, A.A.; Al-Askar, A.A.; Almaary, K.S.; Dawoud, T.M.; Sholkamy, E.N.; Bakri, M.M. Antimicrobial activity of some plant extracts against bacterial strains causing food poisoning diseases. Saudi J. Biol. Sci. 2018, 25, 361–366. [Google Scholar] [CrossRef]
- Chika, C.O.; Jude, N.O.; Ifeanyi, C.O.; Anyanwu, N.B. Antibacterial activities and toxicological potentials of crude ethanolic extracts of Euphorbia hirta. J. Am. Sci. 2007, 3, 11–16. [Google Scholar]
- Nielsen, T.R.; Kuete, V.; Jäger, A.K.; Meyer, J.J.; Lall, N. Antimicrobial activity of selected South African medicinal plants. BMC Complement. Altern Med. 2012, 12, 74. [Google Scholar] [CrossRef]
- Schultes, R.E. Economic Aspects of the Flora of North Eastern Oaxaca, Mexico. Ph.D. Thesis, Harvard University, Cambridge, MA, USA, 1941. [Google Scholar]
- Murashige, T.; Skoog, F.K. A revised medium for rapid growth and bioassays with tobacco tissue cultures. Physiol Plant. 1962, 15, 473–497. [Google Scholar] [CrossRef]
- Boulos, L. Flora of Egypt; AL Hadara publishing: Giza, Egypt, 2005; Volume 4, pp. 33–87. [Google Scholar]
- Kadereit, J.W.; Jeffrey, C. The Families and Genera of Vascular Plants. In VIII Flowering Plants—Eudicots Asterales; Springer: Berlin/Heidelberg, Germany, 2007. [Google Scholar]
- Kumar, N.; Belhumeur, P.N.; Biswas, A.; Jacobs, D.W.; Kress, W.J.; Lopez, I.C.; Soares, J.V.B. Leafsnap: A computer vision system for automatic plant species identification. In Proceedings of the 12th European Conference on Computer Vision (ECCV), Florence, Italy, 7–13 October 2012. [Google Scholar]
- Edwards, K.; Johnstone, C.; Thompson, C. A Simple and Rapid Method for the Preparation of Plant Genomic DNA for PCR Analysis. Nucleic Acids Res. 1991, 19, 1349. [Google Scholar] [CrossRef] [PubMed]
- Saqib, S.; Zaman, W.; Ayaz, A.; Habib, S.; Bahadur, S.; Hussain, S.; Muhammad, S.; Ullah, F. Postharvest disease inhibition in fruit by synthesis and characterization of chitosan iron oxide nanoparticles. Biocatal. Agric. Biotechnol. 2020, 28, 101729. [Google Scholar] [CrossRef]
- Metzenr, H.; Rau, H.; Senger, H. Untersuchungen zur Synchronisierbarkeit einzelner PigmentmangelMutanten von Chlorella. Planta 1965, 65, 186–194. [Google Scholar] [CrossRef]
- Bulda, O.V.; Rassadinab, V.V.; Alekseichuka, H.N.; Laman, N.A. Spectrophotometric Measurement of Carotenes, Xanthophylls, and Chlorophylls in Extracts from Plant Seeds. Russ. J. Plant Physiol. 2008, 55, 544–551. [Google Scholar] [CrossRef]
- Hussien, E.T.; Shaban, S.A.; Ali, O.M.; Seel, H.K.M.; El-Sayed, N.E.A.; Samir, Y.E.; Remaly, G.M.; Mohammed, A.S. Chemical profile and antibacterial activity of Mentha viridis L. essential oils and ethanolic extract. J. Agric. Crop Res. 2021, 9, 34–39. [Google Scholar] [CrossRef]
- Bradford, M.M. A Rapid and Sensitive Method for the Quantitation of Microgram Quantities of Protein Utilizing the Principle of Protein-Dye Binding. Anal. Biochem. 1976, 72, 248–254. [Google Scholar] [CrossRef]
- Wang, M.; Simon, J.E.; Aviles, I.F.; He, K.; Zheng, Q.Y.; Tadmore, Y. Analysis of phenolic compounds in artichoke (Cynara scolymus L.). J. Agric. Food Chem. 2003, 51, 601–608. [Google Scholar] [CrossRef] [PubMed]
- Chang, C.C.; Yang, M.U.; Wen, H.M.; Chern, J.C. Estimation of total flavonoid content in propolis by two complementary colorimetric methods. J. Food Drug Anal. 2002, 10, 178–182. [Google Scholar]
- Adams, R.P. Identification of Essential Oil Components by Gas Chromatography/Mass Spectrometry; Allured Publishing Corp.: Carol Stream, IL, USA, 2001. [Google Scholar]
- Esteban, L.G.; Palacios, P.D. Comparative wood anatomy in Abietoideae (Pinaceae). Bot. J. Linn. Soc. 2009, 160, 184–196. [Google Scholar] [CrossRef]
- Boscaiu, M.; Bacchetta, G.; Güemes, J. Morphological differentiation within the diploid cytotypes of Uriginea maritima s.l. (Hyacinthaceae). Bocconea 2001, 16, 459–555. [Google Scholar]
- Mishra, P.K.; Das, R.K.; Mehta, U.C. Mitotic Study of Radish Grown on Flyash Amended Soil. Crucif. Newsl. 1999, 21, 49–50. [Google Scholar]
- Kavanagh, F. Analytical Microbiology; Kavanagh, F., Ed.; Academic Press: New York, NY, USA; London, UK, 1972; Volume 11. [Google Scholar]
- Shuaib, M.; Zeb, A.; Ali, Z.; Ali, W.; Ahmad, T.; Khan, I. Characterization of Wheat Varieties by Seed Storage Protein Electrophoresis. Afr. J. Biotechnol. 2007, 6, 497–500. [Google Scholar]

| Morphological Parameters | Means ± SD |
|---|---|
| Fresh weight (g) | 2.573 ± 0.0602 |
| Shoot length (cm) | 15.366 ± 1.2503 |
| Branch number | 1.666 ± 0.5773 |
| Root number | 10.000 ± 2.000 |
| Root length (cm) | 13.933 ± 0.3055 |
| Leaf length (cm) | 3.600 ± 0.7810 |
| Leaves number | 3.000 ± 1.000 |
| Leaf weight (g) | 0.3533 ± 0.0351 |
| Physiological Parameter | Concentration (mg/g Fresh wt) |
|---|---|
| Chlorophyll A | 0.2135 ± 0.044 |
| Chlorophyll B | 0.2844 ± 0.042 |
| Carotenoids | 0.6111 ± 0.121 |
| Xanthophyll | 1.9328 ± 0.183 |
| Total Protein | 56.330 ± 15.25 |
| Total Phenolic Compounds | 0.1798 ± 0.024 |
| Total Flavonoids | 0.1404 ± 0.0195 |
| No. | Compound | RT-Min | Area % |
|---|---|---|---|
| 1 | Benzene, 1-ethyl-3-methyl- | 6.266 | 2.77 |
| 2 | Benzene, 1,2,4-trimethyl- | 6.365 | 1.09 |
| 3 | Benzene, 1-ethyl-2-methyl- | 6.545 | 0.50 |
| 4 | Benzene, 1,2,4-trimethyl- | 6.746 | 2.73 |
| 5 | Hexadecanoic acid, trimethylsilyl ester | 19.645 | 1.99 |
| 6 | cis-Vaccenic acid | 22.644 | 31.75 |
| 7 | Pentadec-7-ene, 7-bromomethyl- | 24.734 | 2.67 |
| 8 | Glycidyl palmitate | 25.943 | 2.93 |
| 9 | 9,12-Octadecadienoic acid (Z,Z)-, 2,3-dihydroxypropyl ester | 29.235 | 1.20 |
| 10 | Oleoyl chloride | 29.359 | 6.89 |
| 11 | Octadecanoic acid, 2,3-dihydroxypropyl ester | 30.031 | 0.66 |
| 12 | 9,12-Octadecadienoyl chloride, (Z,Z)- | 30.471 | 3.65 |
| 13 | 9-Octadecenoic acid (Z)-, oxiranylmethyl ester | 30.602 | 23.75 |
| 14 | Glycidyl (Z)-9-Heptadecenoate | 30.775 | 1.50 |
| 15 | Myristic acid glycidyl ester | 31.228 | 1.79 |
| 16 | Bis(2-ethylhexyl) phthalate | 32.510 | 0.77 |
| 17 | .beta.-Sitosterol acetate | 51.052 | 1.45 |
| 18 | .gamma.-Sitosterol | 56.048 | 0.80 |
| 19 | Pentadecafluorooctanoic acid, dodec-2-en-1-yl ester | 59.051 | 0.84 |
| No. | Fraction/Compound | Fragment Size m/z |
|---|---|---|
| 1 | Vanillic acid-O-glucoside | 152 |
| 2 | 7-Hydroxy-naphthalide | 133 |
| 3 | 4-Caffeoylquinic acid | 135 |
| 4 | Methyl-chlorogenic acid | 173 |
| 5 | Dehydroxy-chlorogenic acid | 163 |
| 6 | Roseoside | 153 |
| 7 | Carboxyl-acetyl-rutin | 300 |
Publisher’s Note: MDPI stays neutral with regard to jurisdictional claims in published maps and institutional affiliations. |
© 2022 by the authors. Licensee MDPI, Basel, Switzerland. This article is an open access article distributed under the terms and conditions of the Creative Commons Attribution (CC BY) license (https://creativecommons.org/licenses/by/4.0/).
Share and Cite
Tawfik, E.; Ahmed, M.F.; Albalawi, D.A.; Aljuaid, B.S.; Darwish, D.B.E.; Mahmoud, S.F.; Hassan, K.M.; Ibrahim, M.F.M.; Abdel Razik, A.B. Molecular Identification of Zantedeschia Culture with Determination of Its Morphometric and Metabolic Activities for Mediterranean Acclimatization. Plants 2022, 11, 2311. https://doi.org/10.3390/plants11172311
Tawfik E, Ahmed MF, Albalawi DA, Aljuaid BS, Darwish DBE, Mahmoud SF, Hassan KM, Ibrahim MFM, Abdel Razik AB. Molecular Identification of Zantedeschia Culture with Determination of Its Morphometric and Metabolic Activities for Mediterranean Acclimatization. Plants. 2022; 11(17):2311. https://doi.org/10.3390/plants11172311
Chicago/Turabian StyleTawfik, Eman, Mohamed Fathy Ahmed, Doha A. Albalawi, Bandar S. Aljuaid, Doaa Bahaa Eldin Darwish, Samy F. Mahmoud, Karim M. Hassan, Mohamed F. M. Ibrahim, and Ashraf Bakry Abdel Razik. 2022. "Molecular Identification of Zantedeschia Culture with Determination of Its Morphometric and Metabolic Activities for Mediterranean Acclimatization" Plants 11, no. 17: 2311. https://doi.org/10.3390/plants11172311
APA StyleTawfik, E., Ahmed, M. F., Albalawi, D. A., Aljuaid, B. S., Darwish, D. B. E., Mahmoud, S. F., Hassan, K. M., Ibrahim, M. F. M., & Abdel Razik, A. B. (2022). Molecular Identification of Zantedeschia Culture with Determination of Its Morphometric and Metabolic Activities for Mediterranean Acclimatization. Plants, 11(17), 2311. https://doi.org/10.3390/plants11172311

